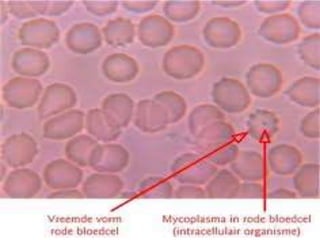
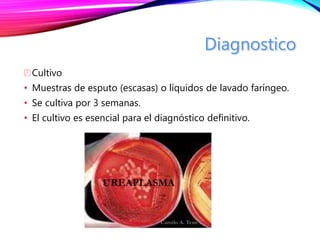
Cultivo
• Muestras de esputo (escasas) o líquidos de lavado faríngeo.
• Se cultiva por 3 semanas.
• El cultivo es esencial para el diagnóstico definitivo.

Mycoplasma y Ureaplasma son las bacterias más pequeñas sin pared celular, presentando resistencia a antibióticos y reproducción por fisión binaria. Estas bacterias son parte de la microbiota normal y pueden ser patógenas, causando infecciones como vaginitis y prostatitis, especialmente en individuos sexualmente activos. El diagnóstico se realiza mediante cultivos y la identificación de síntomas, siendo el tratamiento con antibióticos específico como tetraciclina y eritromicina.